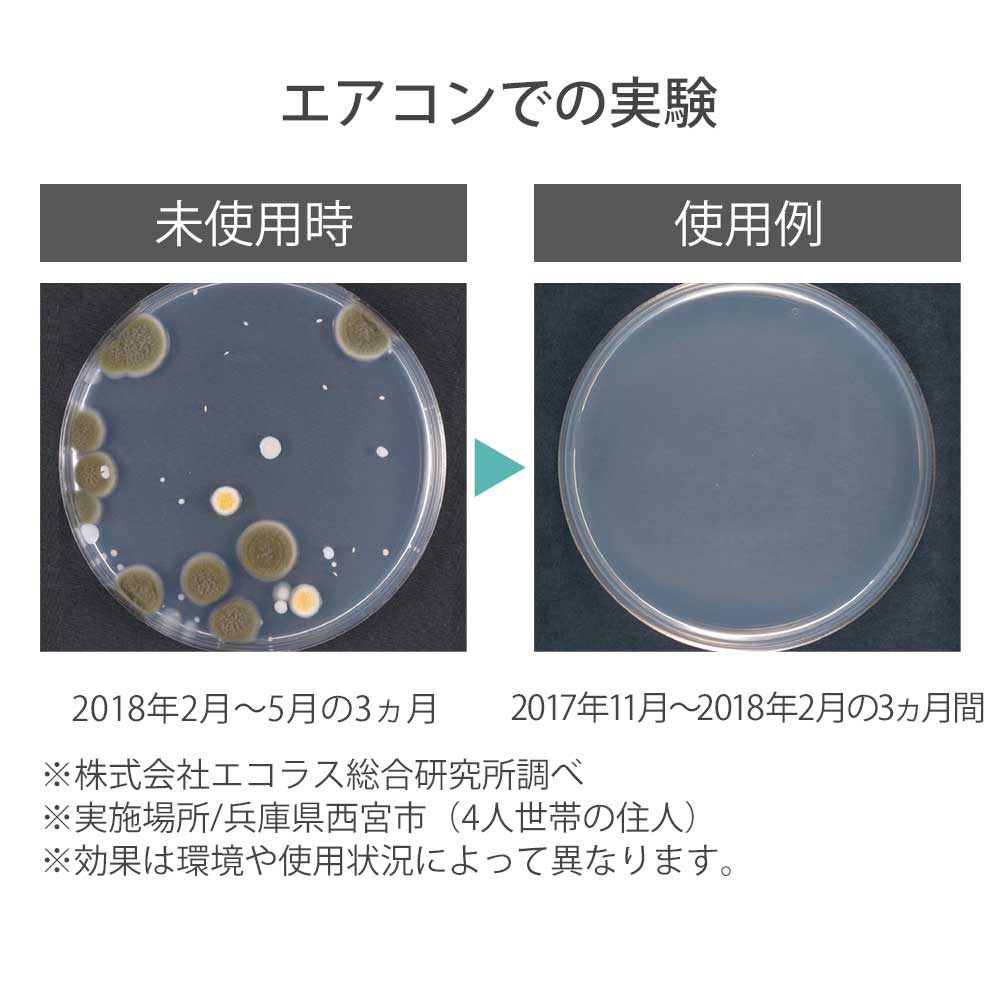
雑貨 パワーバイオ エアコンのカビきれい ファンケルオンライン

カビ取りはカビの性質を知り、徹底的行うことが重要 になります。 カビはカーエアコンの心臓部、エバポレーターが大好き カビは45億年にのぼる地球の歴史の中で、なんと30数億年前には既に誕生していたといわれています。臭いとカビがひどすぎるエアコンを自分で掃除してみた。 素人でもできる! 臭いとカビがひどすぎるエアコンを自分で掃除してみたコジット バイオエアコンのカビきれい バイオの力がエアコンの中をクリーンにしてくれます エアコンの吸気口に貼るだけ! カビや細菌を抑えてキレイな空気に! 交換目安シール付属 効果目安は約3ヶ月です。 使用上の注意 *お子さまの手の届く場所に置かないでください。 *開封時および設置後、しばらくは製品特有のにおいがする場合があります。

Amazon セット買い バイオ エアコンのカビきれい カビ予防 交換目安 約3カ月 お風呂のカビきれい カビ予防 交換目安 約6カ月 コジット ドラッグストア
カビきれい エアコン
カビきれい エアコン-コジット パワーバイオ エアコンのカビきれい 防カビ・消臭 (交換目安3ヶ月) 5つ星のうち38 277 ¥2 ¥2 ¥1,078 ¥1,078 アクエリアスまもる乳酸菌実質無料 パントリーBoxの使用率 10%エアコン 防カビ 通販 パワーバイオ エアコンのカビきれい 4個セット エアコン用 クーラー カビ対策 臭い 消臭 カビ 防止 簡単 掃除 対策 貼るだけ カンタン バイオの力 微生物 掃除グッズ アイデア商品 空調家電用アクセサリー 3,114 円 送料無料




エアコン 防カビ 通販 パワーバイオ エアコンのカビきれい 4個セット エアコン用 クーラー カビ対策 臭い 消臭 カビ 防止 簡単 掃除の通販はau Pay マーケット Backyard Family インテリアタウン Au Pay マーケット店
くうきれい エアコンファン洗浄剤を使ってみての感想 カビはほぼ完全に除去できました 乾燥させる時間も入れると、取扱説明書に書いてあるよりも所要時間は長くなる(合計約90分) 霧吹きは必須(リンスはやはり足りません。 もう3~4本欲しいところコジット パワーバイオ エアコンのカビきれい 防カビ・消臭 (交換目安3ヶ月)がカビ取り剤ストアでいつでもお買い得。当日お急ぎ便対象商品は、当日お届け可能です。アマゾン配送商品は、通常配送無エアコン 防カビ 通販 パワーバイオ エアコンのカビきれい 2個セット エアコン用 クーラー カビ対策 臭い 消臭 カビ 防止 簡単 掃除 対策のネットショッピングは通販サイトau PAY マーケット!送料無料商品やセール商品、レビュー(評判)も多数掲載中。
くうきれい エアコン内部洗浄剤は自分でも簡単にお掃除できる部分「アフミフィン部分」の掃除に使うスプレーです。 「エアコンのカビ」と聞いて、カビなら「カビキラー」と連想する人も多いですが、カビだからと言ってエアコン掃除にカビキラーは カビがひどい時は、 分解掃除 も視野に。 最後に 長文になりましたが、最後まで読んでくださりありがとうございました。 エアコンを掃除すると、空気がきれいに感じて、うれしいですね♪ 気になる汚れを一掃して、気持ちの良い日々をお過ごし バイオ エアコンのカビきれい カビ予防 (交換目安約3カ月 1,315 円 1時間30分
エアコン 防カビ 通販 パワーバイオ エアコンのカビきれい 4個セット エアコン用 クーラー カビ対策 臭い 消臭 カビ 防止 簡単 掃除のネットショッピングは通販サイトau PAY マーケット!送料無料商品やセール商品、レビュー(評判)も多数掲載中。ポイントやクーポンをつかったお買い物もOK!コジット バイオ エアコンのカビきれい・コジット バイオ エアコンのカビきれいコジット バイオ エアコンのカビきれい ( 1コ入(交換目安約3ヵ月) )/ バイオ(BIO) 通販メール便のみ送料無料エアコンの臭いが気になったら貼るだけで解決 バイオエアコンのカビきれいコジットバイオの力 微生物の力 カビ対策 臭い取り 消臭 掃除がラク カビ取り 防カビ カビ防止 便利グッズ 貼るだけ 日本製 メーカー直送(アイデアcom)のレビュー・口コミ情報がご覧




パワーバイオ エアコンのカビきれい



パワーバイオ エアコンのカビきれい Cogit コジット 通販 エアコン用 クーラー バイオの力 カビ対策グッズ 臭い 消臭効果 カビ取り 防カビ カビ防止 Backyard Family Paypayモール 通販 Paypayモール
購入商品バイオ エアコンのカビきれい (エアコン) 思ってたよりいい 冷房のカビ臭さがあったけどつけて2日くらいで消えた。 ただ暖房にするとなんだか納豆系の匂いがする 参考になった(15人) レビューをもっと見る(3/ 1 ) あわせて買いたい商品パワーバイオ エアコンのカビきれい 1個 コジット|LOHACOは最短翌日お届け。PayPayが使える貯まる、アスクルがヤフーと協力して運営するショッピングサイトです。パワーバイオ エアコンのカビきれい ココがポイント! エアコンの気になる臭いや防カビに エアコンの吸気口に貼ってご使用ください 交換目安約3ヶ月 JAN サイズ10×45×厚み08cm 生産国日本 税込 ¥1,078



送料無料 コジット パワーバイオエアコンのカビきれい 共栄会 Jp 本店




送料無料 コジット パワーバイオエアコンのカビきれい 共栄会 Jp 本店
この2つがあります! エアコンのカビが健康に悪影響を及ぼす エアコン掃除をしないと、内部にカビが溜まり、そのカビがエアコンの風と共に部屋に蔓延します。 そのカビを私たちが吸い込んでしまうととても健康に悪いのです。 中には肺炎につながってしまうものも。それが「 くうきれい エアコンファン洗浄剤 (エアコン洗浄剤送風ファン用 養生シート付き)」です。 これはファン内部の汚れに効きます。 泡を充満させてカビを落とします。 ですが、きれいにはがれ落ちるのではなく、 ある程度柔らかくなったらコジット バイオ エアコンのカビきれい(1コ入(交換目安約3ヵ月))の価格比較、最安値比較。最安値 980円(税込)評価:423口コミ:453件(8/14時点 商品価格ナビ)製品詳細:ブランド名:コジット|ブランド名(カナ):コジット




2箱 コジット パワーバイオ エアコンのカビきれい 防カビ 消臭 交換目安 3ヶ月 を税込 送料込でお試し サンプル百貨店 コジット




Amazon バイオ エアコンのカビきれい カビ予防 交換目安 約3カ月 コジット ドラッグストア
エアコンの冷房機能を使用すると、エアコンの内部に結露が発生してエアコン内部の湿度が上がります。 クーラーの使用によって 結露が発生したエアコン内部を乾かすため、冷房運転後は1時間ほど送風運転 を行いましょう。 エアコン内部を乾燥すると、カビの増殖を防げます。 パワーバイオ エアコンのカビきれい 最安価格(税込): ¥766 登録日:19年 7月22日 価格comの安さの理由は? < 1 のユーザーが価格変動や値下がり通知、クチコミ・レビュー通知、購入メモ等を利用中です 価格比較 詳細情報 レビュー クチコミ<パワーバイオ>エアコンのカビきれい 商品詳細 サイズ(約)/幅100×縦45×高さ8mm 材質/中身:珪藻土、微生物(バチルス菌属) ケースポリエチレン




212 Kitchen Store コジット パワーバイオ エアコンのカビきれい Rakuten Fashion 楽天ファッション 旧楽天ブランドアベニュー Cf4191




2箱 コジット パワーバイオ エアコンのカビきれい 防カビ 消臭 交換目安 3ヶ月 を税込 送料込でお試し サンプル百貨店 コジット
コジット COGIT パワーバイオ エアコンのカビきれいの通販ならヨドバシカメラの公式サイト「ヨドバシcom」で!レビュー、Q&A、画像も盛り沢山。ご購入でゴールドポイント取得!今なら日本全国へ全品配達料金無料、即日・翌日お届け実施中。楽天市場「エアコン カビ きれい」5,906件 人気の商品を価格比較・ランキング・レビュー・口コミで検討できます。ご購入でポイント取得がお得。セール商品・送料無料商品も多数。「あす楽」なら翌日お届けも可能です。Woodylabo公式オンラインショップのエアコンカビ 臭い 対策 防カビ 除菌 消臭 エアコン用アロマDE防カビ エレガントアロマ カビ対策 大掃除 カビきれい 貼るだけ 清潔 リビング 寝室 子供部屋 公式ならYahoo!ショッピング!ランキングや口コミも豊富なネット通販。




簡単にエアコンのカビ臭さが改善したよ パワーバイオエアコンのカビきれい で消臭とカビ対策 こころ湯




エアコン 防カビ 通販 パワーバイオ エアコンのカビきれい Backyard Family ポンパレモール




楽天市場 メーカー直送 正規品 エアコンの臭い カビ対策 臭い取り 消臭 カビ取り 防カビ カビ防止 メール便のみ送料無料 バイオエアコンの カビきれい コジット バイオの力 微生物の力 貼るだけ 解決掃除がラク 便利グッズ 貼るだけ 日本製 交換目安約3ヶ月



Ecカレント バイオエアコンのカビきれい の通販価格




楽天市場 メーカー直送 正規品 エアコンの臭い カビ対策 臭い取り 消臭 カビ取り 防カビ カビ防止 メール便のみ送料無料 バイオエアコンの カビきれい コジット バイオの力 微生物の力 貼るだけ 解決掃除がラク 便利グッズ 貼るだけ 日本製 交換目安約3ヶ月




エアコン 防カビ 通販 パワーバイオ エアコンのカビきれい 4個セット エアコン用 クーラー カビ対策 臭い 消臭 カビ 防止 簡単 掃除の通販はau Pay マーケット Backyard Family インテリアタウン Au Pay マーケット店



コジット パワーバイオ エアコンのカビきれい 防カビ バイオ コジット エアコン掃除 ホコリ 湿気 カビ カビ取り きれい 貼るだけ カビ 通販 Lineポイント最大1 0 Get Lineショッピング




コジット パワーバイオ エアコンのカビきれい 防カビ 消臭 2箱セットの通販 By Maき S Shop ラクマ




エアコンのカビきれい カビ予防 カビ防止剤 貼るだけ ちょうキレイ 約2ヶ月




置くだけ簡単 パワーバイオ エアコンのカビきれい 通販のベルメゾンネット




2箱 コジット パワーバイオ 窓のカビきれい 防カビ 消臭 交換目安 3ヶ月 を税込 送料込でお試し サンプル百貨店 コジット




Amazon バイオエアコンのカビきれい カビ取り剤 通販




エアコンに潜むカビが病気の原因 汚れた内部の効果的な掃除方法 Kajily カジリー




楽天市場 パワーバイオエアコンのカビきれい カビ対策 臭い対策 エアコン カビ かび カビ取り 菌 微生物 Bio 冷房 室内 ニオイ 消臭効果 カビ除去 カビ防止 抗カビ効果 クリーン 掃除 両面テープ付 メール便可 便利雑貨のジャストパートナー




Lohaco パワーバイオ エアコンのカビきれい 1セット 2個 コジット




パワーバイオ エアコンのカビきれい 株式会社コジットのエアコンに置いてカビを抑えるグッズ 防カビ防臭アイデア商品 nhkまちかど情報室8月27日 Nhk まちかど情報室今朝の商品



Q Tbn And9gcslxjbhvdsuyhdnvvgoh4h0fjvvdqhymtljnrlkjjx8zv2fcxd1 Usqp Cau




コジット パワーバイオ エアコンのカビきれい 防カビ 消臭 2箱セットの通販 By Maき S Shop ラクマ




防カビ カビ取り エアコン バイオ カビ 消臭 除湿 パワーバイオ エアコンのカビきれい メール便 コジット 便利 キレイの雑貨アイデア Com 通販 Yahoo ショッピング




楽天市場 メーカー直送 正規品 エアコンの消臭 カビ防止 メール便のみ送料無料 パワーバイオエアコンのカビきれい コジット エアコンの臭いが気になったら貼るだけで解決 臭い取り 消臭 掃除がラク カビ取り 防カビ カビ予防 日本製 交換目安3ヵ月 アイデア Com




置くだけ簡単 パワーバイオ エアコンのカビきれい 通販のベルメゾンネット




Amazon コジット パワーバイオ エアコンのカビきれい 防カビ 消臭 交換目安 3ヶ月 コジット カビ取り剤




楽天市場 バイオ エアコンのカビきれいの通販



パワーバイオ エアコンのカビきれい きれいみつけたpaypayモール店 通販 Paypayモール




エアコンが臭い時は バイオエアコンのカビきれい がオススメ トシ




毎日が発見ショッピング パワーバイオ エアコンのカビきれい



1




コジット パワーバイオ エアコンのカビきれい 防カビ 消臭 交換目安 3ヶ月 のレビュー クチコミとして参考になる投稿2枚 Roomclip ルームクリップ



コジット バイオ エアコンのカビきれい 1コ入 交換目安約3ヵ月 バイオ




メール便で送料無料 カビ 防臭 防カビ Cogit エアコン メール便で送料




パワーバイオエアコンのカビきれい Youtube




楽天市場 パワーバイオエアコンのカビきれい カビ対策 臭い対策 エアコン カビ かび カビ取り 菌 微生物 Bio 冷房 室内 ニオイ 消臭効果 カビ除去 カビ防止 抗カビ効果 クリーン 掃除 両面テープ付 メール便可 便利雑貨のジャストパートナー




貼るだけでエアコンのカビを防ぐ パワーバイオエアコンのカビきれい




Amazon セット品 バイオ エアコンのカビきれい カビ予防 交換目安 約3カ月 3個 コジット カビ取り剤




コレ貼るだけでカビの不安なくなるってスゴくない マイ定番スタイル Roomie ルーミー



防カビ カビ取り エアコン バイオ カビ 消臭 除湿 パワーバイオ エアコンのカビきれい メール便 コジット 便利 キレイの雑貨アイデア Com 通販 Yahoo ショッピング




バイオ エアコンのカビきれい エアコン 通販 ニトリネット 公式 家具 インテリア通販



防カビ カビ取り エアコン カビ 消臭 除湿 バイオエアコンのカビきれい メール便 コジット 0227 便利 キレイの雑貨アイデア Com 通販 Yahoo ショッピング




Amazon セット買い バイオ エアコンのカビきれい カビ予防 交換目安 約3カ月 お風呂のカビきれい カビ予防 交換目安 約6カ月 コジット ドラッグストア




コジット バイオ エアコンのカビきれい 2個セットの中古 未使用品を探そう メルカリ




メール便で送料無料 コジット バイオエアコンのカビきれい ホーム キッチン 生活雑貨 日用品 にっぽん津々浦々 本店




Lohaco パワーバイオ エアコンのカビきれい 1セット 2個 コジット



コジット パワーバイオ エアコンのカビきれい 2個 メール便で送料無料 にっぽん津々浦々 通販 Paypayモール




ヨドバシ Com コジット Cogit バイオ エアコンのカビきれい B00cdgn0si 通販 全品無料配達




Amazon バイオ エアコンのカビきれい カビ予防 交換目安 約3カ月 コジット ドラッグストア



防カビ パワーバイオ エアコン用 カビ 抑制 防止 対策 臭い対策 カビの繁殖 抑える




2箱 コジット パワーバイオ エアコンのカビきれい 防カビ 消臭 交換目安 3ヶ月 を税込 送料込でお試し サンプル百貨店 コジット




Amazon コジット パワーバイオ エアコンのカビきれい 防カビ 消臭 交換目安 3ヶ月 4個 コジット カビ取り剤




Amazon セット買い バイオ エアコンのカビきれい カビ予防 交換目安 約3カ月 お風呂のカビきれい カビ予防 交換目安 約6カ月 コジット ドラッグストア




コジット バイオ エアコンのカビきれい オークション比較 価格 Com




パワーバイオ エアコンのカビきれい Mamadaysショップ




Amazon セット買い コジット パワーバイオ エアコンのカビきれい 防カビ 消臭 交換目安 3ヶ月 バイオ お風呂のカビきれい カビ予防 交換目安 約6カ月 コジット カビ取り剤



Q Tbn And9gcti6sfnftah7s9cirrfn9bbsqcxjjprjvbttvh9sidyefcr3v9d Usqp Cau




貼るだけでエアコンのカビを防ぐ パワーバイオエアコンのカビきれい




バイオ エアコンのカビきれい カビ予防 交換目安 約3カ月 コジット ドラッグストア Amazon




貼るだけでエアコンのカビを防ぐ パワーバイオエアコンのカビきれい



防カビ カビ取り エアコン カビ 消臭 除湿 バイオエアコンのカビきれい メール便 コジット 0227 便利 キレイの雑貨アイデア Com 通販 Yahoo ショッピング




メール便で送料無料 コジット パワーバイオ エアコンのカビきれい 2個 ホーム キッチン 生活雑貨 日用品 にっぽん津々浦々 本店




置くだけ簡単 パワーバイオ エアコンのカビきれい 通販のベルメゾンネット




コジット パワーバイオ エアコンのカビきれい 浴室 風呂掃除グッズ 風呂用カビ取り剤 東急ハンズネットストア



Q Tbn And9gcqkk5133f69nsuqrb2bq9 Pplgisrlflooifgqqjvnxi5zzmtiv Usqp Cau




エアコンにカビが生えなくなる魔法のアイテム バイオ エアコンのカビきれい 昨夏経過後レビュー ノマサラ




パワーバイオ エアコンのカビきれい 株式会社コジットのエアコンに置いてカビを抑えるグッズ 防カビ防臭アイデア商品 nhkまちかど情報室8月27日 Nhk まちかど情報室今朝の商品




Amazon コジット バイオ エアコンのカビきれい 2個セット Bio カビ取り剤




パワーバイオエアコンのカビきれい 通販 ニッセン




貼るだけでエアコンのカビを防ぐ パワーバイオエアコンのカビきれい



防カビ カビ取り エアコン カビ 消臭 除湿 バイオエアコンのカビきれい メール便 コジット 0227 便利 キレイの雑貨アイデア Com 通販 Yahoo ショッピング




コジット バイオエアコンのカビきれい 2個を税込 送料込でお試し サンプル百貨店 株式会社コジット



防カビ カビ取り エアコン バイオ カビ 消臭 除湿 パワーバイオ エアコンのカビきれい メール便 コジット Buyee Buyee Japanese Proxy Service Buy From Japan Bot Online




簡単にエアコンのカビ臭さが改善したよ パワーバイオエアコンのカビきれい で消臭とカビ対策 こころ湯




Amazon バイオ エアコンのカビきれい カビ予防 交換目安 約3カ月 コジット ドラッグストア



消臭 防カビ 効果アップ 貼るだけ 天然 バイオ エアコン カビ パワーバイオ エアコンのカビきれい コジット




Qoo10 パワーバイオ エアコンのカビきれい Co 季節家電




エアコン 防カビ 通販 パワーバイオ エアコンのカビきれい 4個セット エアコン用 クーラー カビ対策 臭い 消臭 カビ 防止 簡単 掃除の通販はau Pay マーケット Backyard Family ママタウン Au Pay マーケット店

雑貨 パワーバイオ エアコンのカビきれい ファンケルオンライン




Amazon バイオ エアコンのカビきれい カビ予防 交換目安 約3カ月 コジット ドラッグストア



パワーバイオ エアコンのカビきれい Mamadaysショップ




パワーバイオ エアコンのカビきれい Cogit コジット 通 Backyard Family ポンパレモール




Amazon セット品 バイオ エアコンのカビきれい カビ予防 交換目安 約3カ月 3個 コジット カビ取り剤




コジット バイオ エアコンのカビきれい 2個セットの中古 未使用品を探そう メルカリ



エアコン用 Bioのカビバリア エアコン カビ きれい キレイ カビ防止 臭い ニオイ メール便対応 すまいる雑貨 Yahoo 店 通販 Yahoo ショッピング




貼るだけでエアコンのカビを防ぐ パワーバイオエアコンのカビきれい




エアコンが臭い時は バイオエアコンのカビきれい がオススメ トシ




Amazon コジット パワーバイオ エアコンのカビきれい 防カビ 消臭 交換目安 3ヶ月 コジット カビ取り剤




バイオ エアコンのカビきれい カビ予防 交換目安 約3カ月 リコメン堂 ポンパレモール




貼るだけでエアコンのカビを防ぐ パワーバイオエアコンのカビきれい




エアコン 防カビ 通販 パワーバイオ エアコンのカビきれい 2個セット エアコン用 クーラー カビ対策 臭い 消臭 カビ 防止 簡単 掃除の通販はau Pay マーケット Backyard Family インテリアタウン Au Pay マーケット店




パワーバイオ エアコンのカビきれい Cogit コジット 通 Backyard Family ポンパレモール




貼るだけでエアコンのカビを防ぐ パワーバイオエアコンのカビきれい




貼るだけでエアコンのカビを防ぐ パワーバイオエアコンのカビきれい




パワーバイオ エアコンのカビきれい 2個セットの通販 By Maき S Shop ラクマ




Amazon コジット パワーバイオ エアコンのカビきれい 防カビ 消臭 交換目安 3ヶ月 4個 コジット カビ取り剤




Amazon コジット パワーバイオ エアコンのカビきれい 防カビ 消臭 交換目安 3ヶ月 2個 コジット カビ取り剤




エアコンのカビきれい カビ予防 カビ防止剤 貼るだけ ちょうキレイ 約2ヶ月 1個入 防カビ 抗菌の通販はau Pay マーケット カナエミナ




貼るだけでエアコンのカビを防ぐ パワーバイオエアコンのカビきれい




エアコン 防カビ 通販 パワーバイオ エアコンのカビきれい Backyard Family ポンパレモール